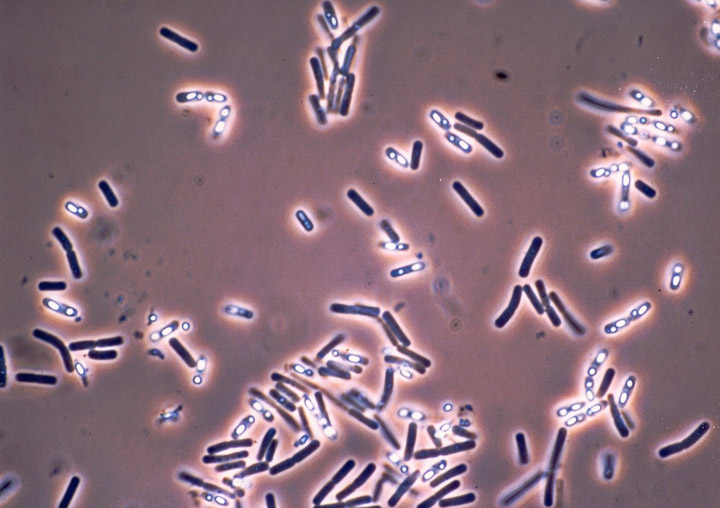

La Universitat de València, cuarta en el ranking mundial de publicaciones científicas sobre una bacteria clave en muchos insecticidas
- Gabinete de Prensa
- 18 noviembre de 2022
La Universitat de València se encuentra en cuarta posición mundial en número de publicaciones científicas sobre las aplicaciones de la bacteria Bacillus thuringiensis y sus proteínas insecticidas. También es la octava por el número de citas recibidas por esas publicaciones, un hecho que confirma el impacto en el estudio de esta bacteria presente en muchos insecticidas. Algunas publicaciones de la Universitat de València están entre las 10 que han recibido más citas y entre las 20 que han resultado claves al impulsar la investigación en algún aspecto de este campo.
Especialmente desde los años 1960, Bacillus thuringiensis se ha utilizado en la agricultura y, más tarde, en el control de las poblaciones de mosquitos, para ser el componente activo de muchos bioinsecticidas. Esta bacteria produce unas proteínas que, en algunos de sus aislados, poseen una alta toxicidad contra insectos. Además, tienen tanta especificidad que no afectan la fauna beneficiosa y por eso son un buen elemento a incluir en el control integrado de plagas, especialmente en la agricultura ecológica.
El interés en esta bacteria disfrutó un gran impulso cuando, a finales de los ochenta, se demostró que los genes que codificaban las proteínas insecticidas podían ser expresados en plantas, que las protegía así contra el ataque de los insectos. Fue el comienzo de los cultivos transgénicos que, desde 1996, se comercializan en todo el mundo, siendo los cultivos-Bt (aquellos que expresan proteínas de esta bacteria y que son resistentes a insectos) los que ocupan casi la mitad del área mundial dedicada a los cultivos transgénicos.
A pesar de la reticencia de la Unión Europea (UE) a estos tipos de cultivos biotecnológicos de nueva generación, España es el país de la UE que más extensión dedica a cultivos-Bt (maíz-Bt, el único cultivo transgénico que la UE aprobó y que desde entonces, no ha vuelto a aprobar ninguno más).
El ranking ahora difundido ha analizado 5.757 publicaciones (solo artículos científicos y revisiones; el 98,2% de ellas en inglés) que se encuentran indexadas en la Web of Science Core Collection desde 1980 hasta 2021. Se puede ver la noticia completa en: https://orcid.org/0000-0003-1890-7500
Archivada en: Investigació a la UV

.png)














